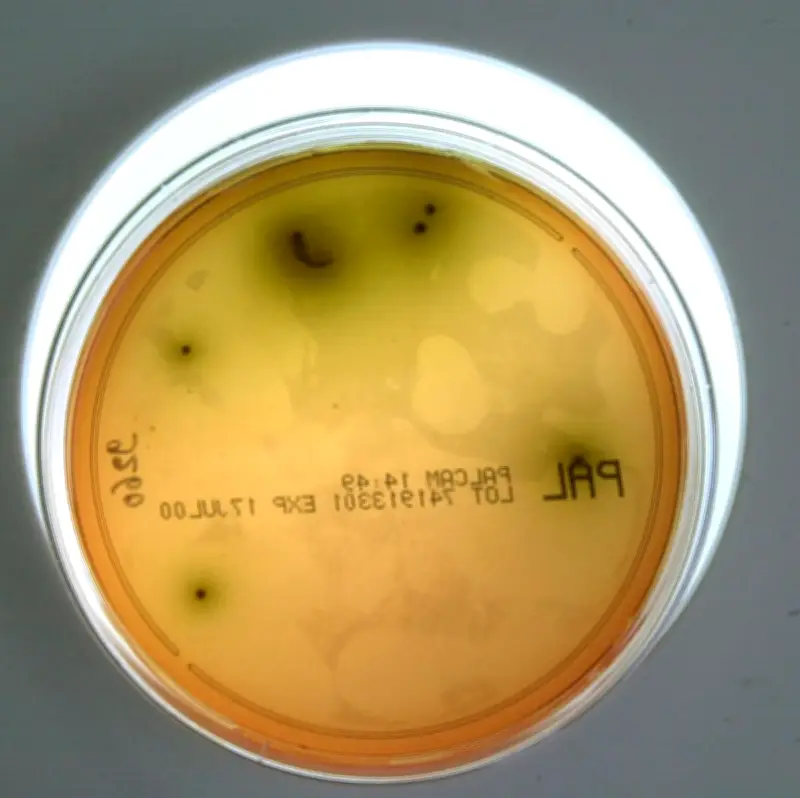

Listériose en Drôme : une contamination alimentaire fait deux victimes
Les autorités sanitaires françaises ont annoncé jeudi une série de cas graves de listériose liés à des produits de charcuterie. Douze personnes ont été infectées entre septembre 2025 et janvier 2026, et deux d'entre elles, âgées de plus de 75 ans, sont malheureusement décédées des suites de cette intoxication alimentaire.
Une entreprise de la Drôme mise en cause
Les ministères de l'Agriculture et de la Santé, en collaboration avec Santé publique France, ont identifié l'origine de la contamination. Tous les cas sont liés à des charcuteries produites par l'entreprise Drôme Ardèche Tradition, située à Bourg-de-Péage dans le département de la Drôme. Cette entreprise artisanale spécialisée dans les produits de tradition régionale est au cœur de l'enquête sanitaire.
Mesures d'urgence et rappel des produits
Face à cette situation critique, les autorités ont pris des mesures immédiates et drastiques :
- Un arrêté préfectoral de suspension d'activité a été émis contre l'entreprise.
- Drôme Ardèche Tradition a procédé au retrait et au rappel de tous les produits fabriqués sur son site de production.
- Ces opérations se déroulent sous la supervision étroite des services de l'État pour garantir leur efficacité.
Le communiqué conjoint des ministères insiste sur la vigilance nécessaire concernant les produits de cette marque. Les consommateurs qui détiendraient des charcuteries de Drôme Ardèche Tradition sont invités à ne pas les consommer et à les rapporter immédiatement à leur point de vente.
La listériose, une infection potentiellement grave
La listériose est une infection bactérienne causée par Listeria monocytogenes. Elle se transmet principalement par l'ingestion d'aliments contaminés. Si elle peut passer inaperçue chez les personnes en bonne santé, elle représente un danger majeur pour :
- Les personnes âgées, dont le système immunitaire est affaibli.
- Les femmes enceintes, avec des risques pour le fœtus.
- Les nourrissons et les individus immunodéprimés.
Les symptômes incluent fièvre, maux de tête, et dans les formes graves, méningite ou septicémie. Les deux décès survenus dans cette affaire soulignent la nécessité d'une surveillance sanitaire renforcée dans l'industrie agroalimentaire, notamment pour les produits sensibles comme les charcuteries.









